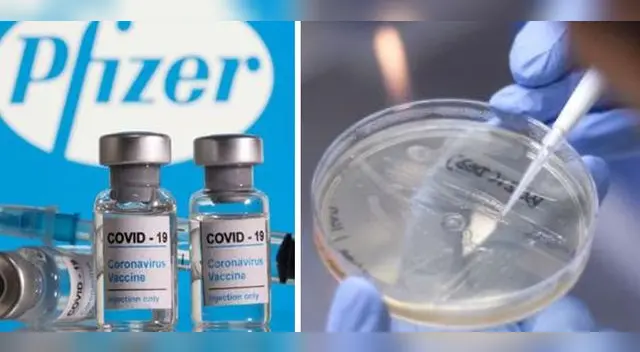
Vacuna de Pfizer es “ligeramente” menos efectiva contra la variante india del coronavirus, afirma estudio

Vacuna de Pfizer es “ligeramente” menos efectiva contra la variante india del coronavirus, afirma estudio
El estudio del Instituto Pasteur de París sostiene que la vacuna de Pfizer funciona frente a variante india, pero cuenta con una eficacia “ligeramente menor”.
Únete al canal de Whatsapp de El Popular- Alerta sanitaria en EE. UU.: aumentan los CASOS de Influenza A H3N2 y estos son sus síntomas
- "Cuenta Trump" para niños : Estos son los beneficiarios que recibirán $1000 en EE.UU.
La vacuna contra el coronavirus desarrollada por la farmacéutica estadounidense de Pfizer generaría anticuerpos capaces de neutralizar a la variante “doble mutante”, detectada en la India, según señala un estudio del Instituto Pasteur de París.
La investigación publicada en el repositorio científico de BioRxiv sostiene que se trata de una “eficacia ligeramente menor”, A pesar de ello, las pruebas de laboratorio demostraron que la vacuna Pfizer es probablemente protectora contra la variante india.
Asimismo, los expertos detectaron que la vacuna de Pfizer cuenta con una mayor efectividad contra la variante británica del coronavirus, pero con menos efectividad en la variante india, que según la Organización Mundial de la Salud (OMS), se ya encuentra en 53 países del mundo.
Cabe resaltar que, a diferencia de este estudio, el organismo de sanidad pública en Inglaterra, Public Health England, señaló que las vacunas contra el coronavirus de Pfizer y AstraZeneca son “altamente efectivas” contra la variante india del virus.
Efectividad de Pfizer contra la COVID-19
La vacuna de Pfizer y BioNTech contra el coronavirus posee una efectividad del 95%, en adultos, en la prevención de infecciones, según los resultados de la fase III de los ensayos clínicos.

Variante del coronavirus en la India
Esta variante del coronavirus fue descubierta en la India, exactamente en el estado indio Maharashtra, a través de una secuenciación genómica del virus. "El análisis de muestras de Maharashtra ha revelado que, en comparación con diciembre de 2020, ha habido un aumento en la fracción de muestras con las mutaciones E484Q y L452R", manifestó el informe INSACOG, consorcio indio formado por el Ministerio de Salud y Bienestar Familiar.

Revisa todas las noticias escritas por el staff de redactores de El Popular.







